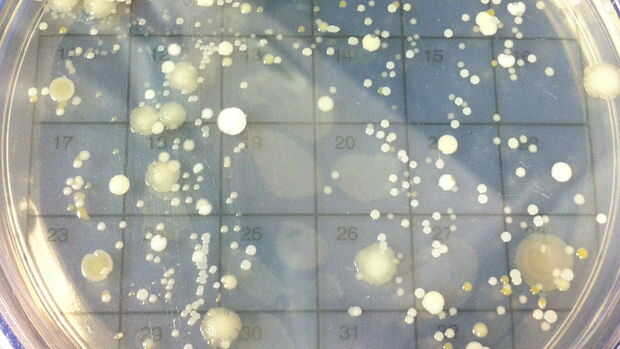

Paso 3: Variables

-Independiente (manipulada) Variable - chupete materiales y los métodos de limpieza (ninguno vs limpieza hogar vs esterilización).
-Dependientes (responder) Variable - crecimiento bacteriano.
-Controles - 6 chupetes unsucked (1 de cada material para cada condición de ensayo).